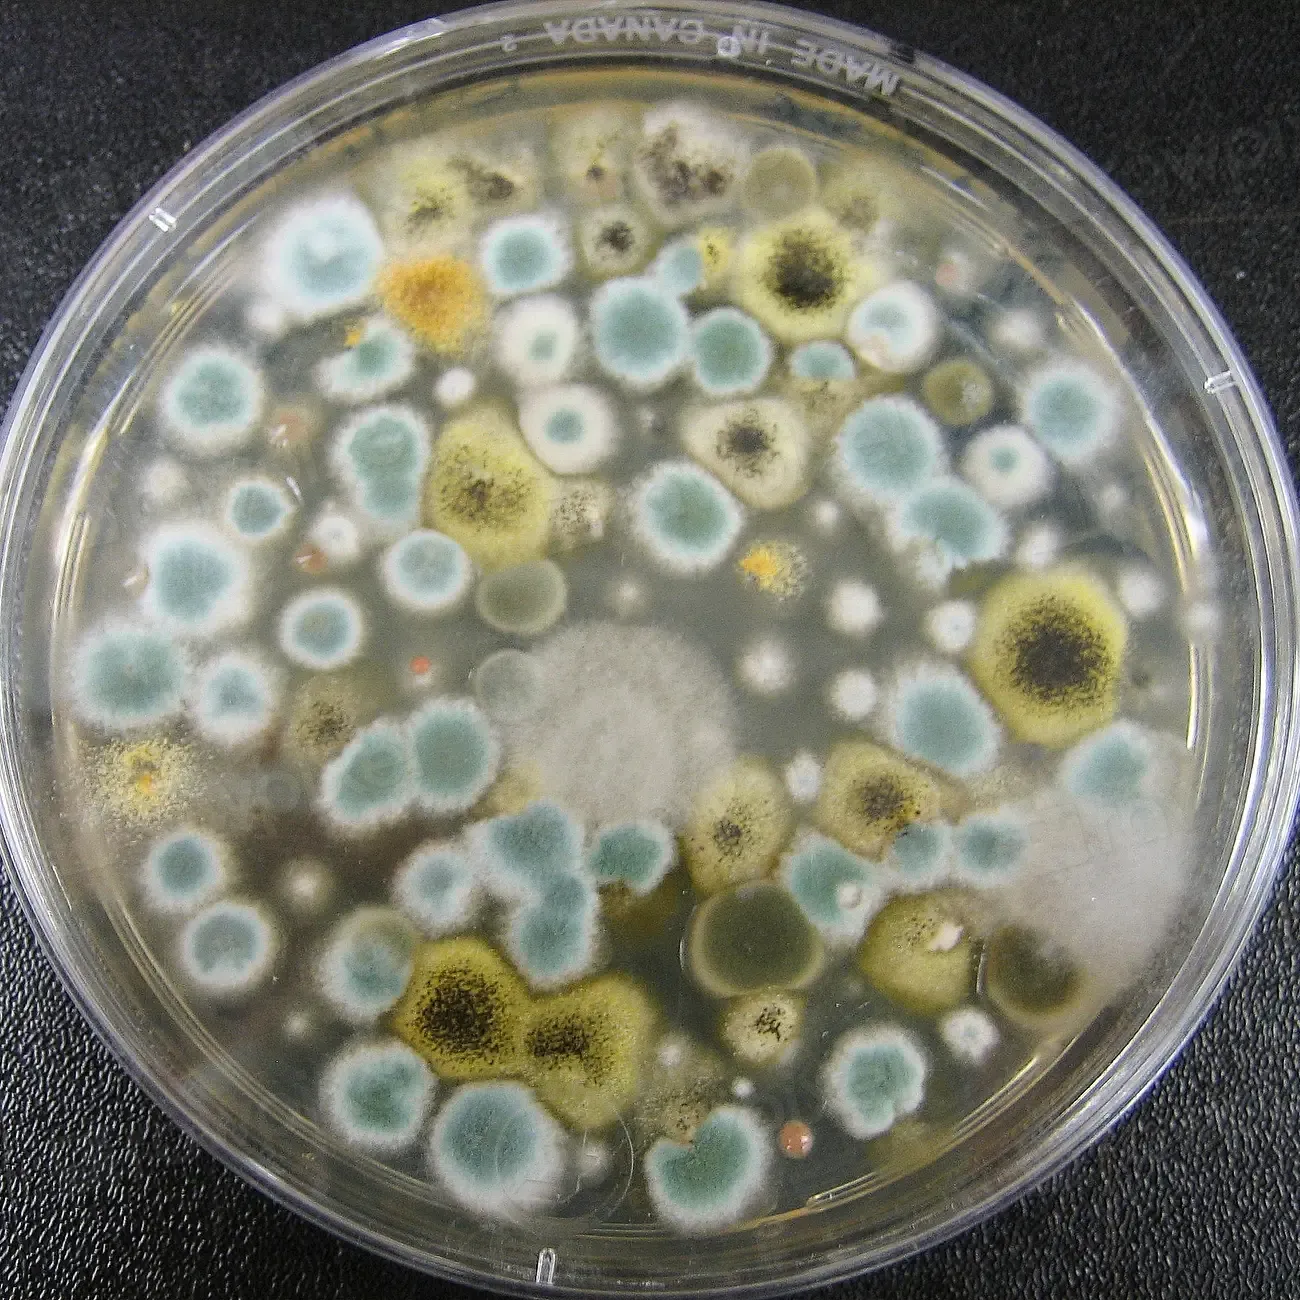
Microbial Frontiers: The Biggest Wave of “New Species” (Image Credits: Rawpixel)

The planet is not waiting for us to catch up. While we argue about climate targets and trade policies, evolution and discovery keep quietly rewriting the catalog of life on Earth. In labs, on coral reefs, in cloud forests, and even in city gutters, scientists are racing to name species before they disappear, or before we even realize they were there. The real twist is that many of the “new” organisms we’ll hear about in 2026 are not freshly evolved aliens, but long-hidden neighbors finally revealed by better tools. The story of new life emerging is as much about our changing technology and imagination as it is about the organisms themselves. The mystery is not whether new species will be found, but which ones we’ll notice in time.
The Hidden Clues: How We Actually Find “New” Life

It sounds dramatic to say a new species has just emerged, but in most cases the creature has been there for thousands or even millions of years, disguised by our ignorance. Field biologists talk about “cryptic diversity,” when two organisms look nearly identical but are genetically and ecologically distinct. In tropical forests, for instance, what was long labeled as a single frog or butterfly can turn out to be half a dozen closely related species once scientists examine their DNA and calls. It’s like realizing the cast of a movie you thought had one lead actor actually has an ensemble playing nearly the same role. Every season of fieldwork, new sets of these hidden players step out of the background and onto the scientific stage.
Even in familiar landscapes, clues are hiding in plain sight: subtly different wing patterns, slightly shifted flowering times, or unique chemical traces in soil and water. Ecologists now treat those small differences as signals, not noise, and build careful case files for each candidate species. By 2026, many of the “new” organisms making headlines will have been recognized first not by a dramatic discovery expedition, but by a careful re-reading of old museum specimens and field notes. The detective work is slow and rarely glamorous, but it is steadily exposing a far more crowded and complicated tree of life than we once imagined.
From Ancient Tools to Genomic Superpowers

From Ancient Tools to Genomic Superpowers (Image Credits: Wikimedia)
For most of human history, species discovery was done with eyes, hands, and paper labels. Naturalists would compare bones, feathers, and leaves, sketch what they saw, and argue about whether a strange bird was truly new or just a scruffy version of a known one. That tradition is still very much alive, but it has been turbocharged by genetics and computing power. Today, a few drops of blood or a sliver of tissue can reveal deep evolutionary histories and subtle splits between species that look almost identical. Where nineteenth-century scientists might squint at a beetle under glass, modern taxonomists scroll through DNA sequences on their laptops.
By 2026, this shift to genomic tools means the rate of described species is not just continuing; in some groups it is accelerating. Researchers use techniques like “DNA barcoding” to rapidly scan thousands of specimens from museums and field surveys, flagging unexpected genetic lineages that probably deserve species status. Environmental DNA, or eDNA, lets scientists filter water or soil and find genetic traces of creatures that never show themselves directly. That means rivers, air filters in buildings, and even puddles on a city street can become sampling sites for hidden biodiversity. The result is a steady stream of papers announcing freshwater fishes, microscopic fungi, and tiny invertebrates that no one previously knew existed, even in well-studied regions.
New Species Emerging in a Warming World

New Species Emerging in a Warming World (Image Credits: Unsplash)
Climate change is not just shrinking habitats; it is also reshaping how and where life evolves. As temperature zones shift toward the poles and up mountainsides, populations that were once separated begin colliding, and others get isolated on shrinking “islands” of suitable climate. Isolated populations are the raw material for speciation, the long-term process where one lineage splits into two or more distinct species. In the coming years, especially around 2026 and beyond, scientists expect to document more examples of organisms caught in the act of splitting: insects with diverging behaviors, plants evolving new flowering times, or fish adapting to unusual temperature regimes.
At the same time, our fast-changing landscapes create strange new arenas for evolution in real time. Urban heat islands, polluted waterways, and novel food sources in cities give rise to animals and plants that are genetically distinct from their rural relatives. Biologists already see this in some city-dwelling birds, insects, and even weeds whose genes show they are adapting specifically to concrete, glass, and artificial light. While these urban lineages are not always called full species yet, they are headed down that path, and by 2026 more of them may cross the threshold in formal scientific classifications. It is a paradoxical picture: the same forces pushing many species toward extinction are nudging others along the earliest stages of becoming new ones.
Microbial Frontiers: The Biggest Wave of “New Species”
Microbial Frontiers: The Biggest Wave of “New Species” (Image Credits: Rawpixel)
If you picture new species as colorful birds or charismatic mammals, you are missing the main story. The vast majority of undiscovered life is microscopic: bacteria, archaea, tiny protists, and fungi that form the invisible scaffolding of ecosystems. Microbiologists often say that what we know about microbes is like sampling a cup of water from the ocean and pretending we now understand the whole sea. Every new deep-sea drilling core, hot spring sample, and gut microbiome survey uncovers lineages so different from known organisms that they force textbooks to be rewritten. Some recent discoveries have even blurred the line between what we thought belonged in separate domains of life.
By 2026, genome sequencing will continue to flood databases with thousands of newly named microbial species each year. Many of these microbes perform quiet but critical roles in carbon cycling, nitrogen fixation, and even influencing local weather through tiny particles they release into the air. A few end up in the spotlight because they matter directly to human health, agriculture, or climate models. For example, certain newly identified microbes can help crops tolerate drought, while others break down pollutants in ways we did not anticipate. The most surprising twist is that some entirely new lineages of microbes are being found not in remote jungles, but in hospital plumbing, subway systems, and wastewater treatment plants, reminding us that unexplored frontiers exist under our feet.
Why It Matters: More Than Just New Names

Why It Matters: More Than Just New Names (Image Credits: Unsplash)
It’s easy to dismiss all this as scientists arguing over labels, but each new species that gets formally described is a doorway into understanding how the world really works. When biologists recognize that what they thought was one insect is actually three different species, it can transform pest management strategies, pollination studies, and conservation plans. Discovering a new amphibian can reveal a hidden wetland system that purifies water or serves as a buffer against floods. In that sense, species descriptions are not just academic exercises; they are practical maps for navigating a complex planet.
Compared with the early natural history era, today’s discoveries often arrive with direct implications for human survival. Knowing the true diversity of mosquitoes, for instance, shapes how we track disease; recognizing distinct coral species changes how we protect reefs amid warming seas. This makes new species a kind of early-warning system: when we see them disappearing or shifting ranges, we get clues about ecosystem stress long before crops fail or fisheries collapse. There is also an ethical dimension that scientists increasingly emphasize. If we do not even know what is out there, how can we pretend to be responsible stewards of the only biosphere we have?
Global Perspectives: Discovery Hotspots and Gaps

Global Perspectives: Discovery Hotspots and Gaps (Image Credits: Wikimedia)
New species announcements often sound like they are always coming from the same handful of tropical forests or coral reefs, but the global picture is more complicated. Biodiversity hotspots in South America, Southeast Asia, and parts of Africa do lead the way in raw numbers, particularly for plants, amphibians, and insects. Yet scientists keep finding surprises in temperate regions, high latitudes, and deep underground as well. Newly recognized cave fishes, alpine flowers, and soil fungi highlight how even countries with long scientific traditions still harbor major blind spots. It’s a bit like assuming you know every room in your house, then discovering a hidden staircase in the wall.
There are also glaring geographic and political gaps in our knowledge. Regions affected by conflict, economic instability, or limited scientific funding remain under-sampled, which means their species stay invisible. Indigenous and local communities often hold detailed knowledge of organisms long before they receive Latin names, and in recent years there has been a push to center that knowledge in discovery efforts. By 2026, some of the most meaningful “new species” stories may come from collaborations that bridge traditional ecological knowledge with genomic tools. When those worlds meet, the result is not just a new name on a checklist, but a deeper narrative about place, culture, and long-standing relationships with the living world.
The Future Landscape: How Technology Will Shape 2026 Discoveries

The Future Landscape: How Technology Will Shape 2026 Discoveries (Image Credits: Unsplash)
Looking ahead to 2026, the way we detect new species is likely to feel even more like science fiction. Autonomous underwater vehicles will patrol deep reefs and seamounts, recording video and collecting water samples rich in environmental DNA. Drones equipped with hyperspectral sensors will scan forest canopies, picking up subtle changes in leaf chemistry that hint at different plant species. Artificial intelligence systems will sift through camera trap images and audio recordings, flagging unusual calls or body shapes that do not match known species. In effect, we are building a distributed nervous system for the planet, constantly listening and watching for biological anomalies.
Alongside the excitement, there are real challenges. Vast amounts of sequence data are already piling up faster than taxonomists can formally name and describe the organisms they represent. Some scientists worry about a growing gap between “detected biodiversity” and “understood biodiversity,” where we have hints that something exists but little knowledge of its ecology or vulnerability. There are also ethical questions about who controls genetic data, especially when it comes from biodiversity-rich countries with long histories of being mined for resources. The choices we make about funding taxonomy, sharing data, and involving local communities will determine whether the next wave of discoveries deepens global equity or repeats old patterns of extraction.
Everyday Encounters: New Life in Familiar Places

Everyday Encounters: New Life in Familiar Places (Image Credits: Wikimedia)
One of the most surprising shifts in recent years is how often new species are first noticed by non-scientists. Citizen science platforms and simple smartphone cameras routinely capture images of unusual spiders, lichens, or beetles that later turn out to be undescribed. I still remember the mild shock of realizing that a humble moss in a cracked sidewalk, which I had walked past for years, was part of a group undergoing taxonomic revision that would likely split it into several new species. That feeling – that the ordinary might secretly be extraordinary – is becoming a common part of the biodiversity story. It makes the idea of “new life in 2026” feel less like a distant expedition and more like something happening in our own backyards.
Urban biodiversity surveys are revealing patterns that would have been dismissed as fantasy just a generation ago. City parks host distinct communities of insects compared with nearby countryside, and high-rise rooftops act as islands where plants and invertebrates follow their own evolutionary scripts. By 2026, new species from these human-dominated landscapes will probably continue to appear in scientific journals, blurring the old line between “wild” and “built” environments. That shift forces us to rethink what counts as nature and where we should look for it. It suggests that being attentive, even on a daily commute, can be a genuine act of scientific engagement.
What You Can Do: Helping New Species Be Seen, Not Lost

What You Can Do: Helping New Species Be Seen, Not Lost (Image Credits: Wikimedia)
For most of us, the idea of describing a new species sounds like something reserved for remote expeditions and lab coats, but there are straightforward ways to be part of this unfolding story. The simplest is to pay closer attention and document what you see: uploading photos of plants, fungi, insects, and other organisms to community science platforms gives researchers an enormous, living dataset. Regular contributions from ordinary people have already expanded known ranges for many species and flagged organisms that turned out to be new to science. Joining local bioblitzes, nature walks, or urban biodiversity surveys adds your eyes and ears to that collective effort. It turns curiosity into a form of data collection.
Supporting organizations that protect habitats is another powerful step, because undiscovered species are often clustered in places under threat. Donations, volunteer time, and even political advocacy for conservation policies all help keep the stage intact for this rich cast of life. Education also matters: sharing stories about new species with friends, schools, or community groups helps shift the narrative from despair to informed wonder. As we move into 2026, the question is not whether new species will emerge into human awareness, but whether we will create the conditions for them to thrive once they are recognized. In a world where discovery and extinction now race side by side, the simplest acts of attention and care can make a quiet but crucial difference.

Suhail Ahmed is a passionate digital professional and nature enthusiast with over 8 years of experience in content strategy, SEO, web development, and digital operations. Alongside his freelance journey, Suhail actively contributes to nature and wildlife platforms like Discover Wildlife, where he channels his curiosity for the planet into engaging, educational storytelling.
With a strong background in managing digital ecosystems — from ecommerce stores and WordPress websites to social media and automation — Suhail merges technical precision with creative insight. His content reflects a rare balance: SEO-friendly yet deeply human, data-informed yet emotionally resonant.
Driven by a love for discovery and storytelling, Suhail believes in using digital platforms to amplify causes that matter — especially those protecting Earth’s biodiversity and inspiring sustainable living. Whether he’s managing online projects or crafting wildlife content, his goal remains the same: to inform, inspire, and leave a positive digital footprint.



